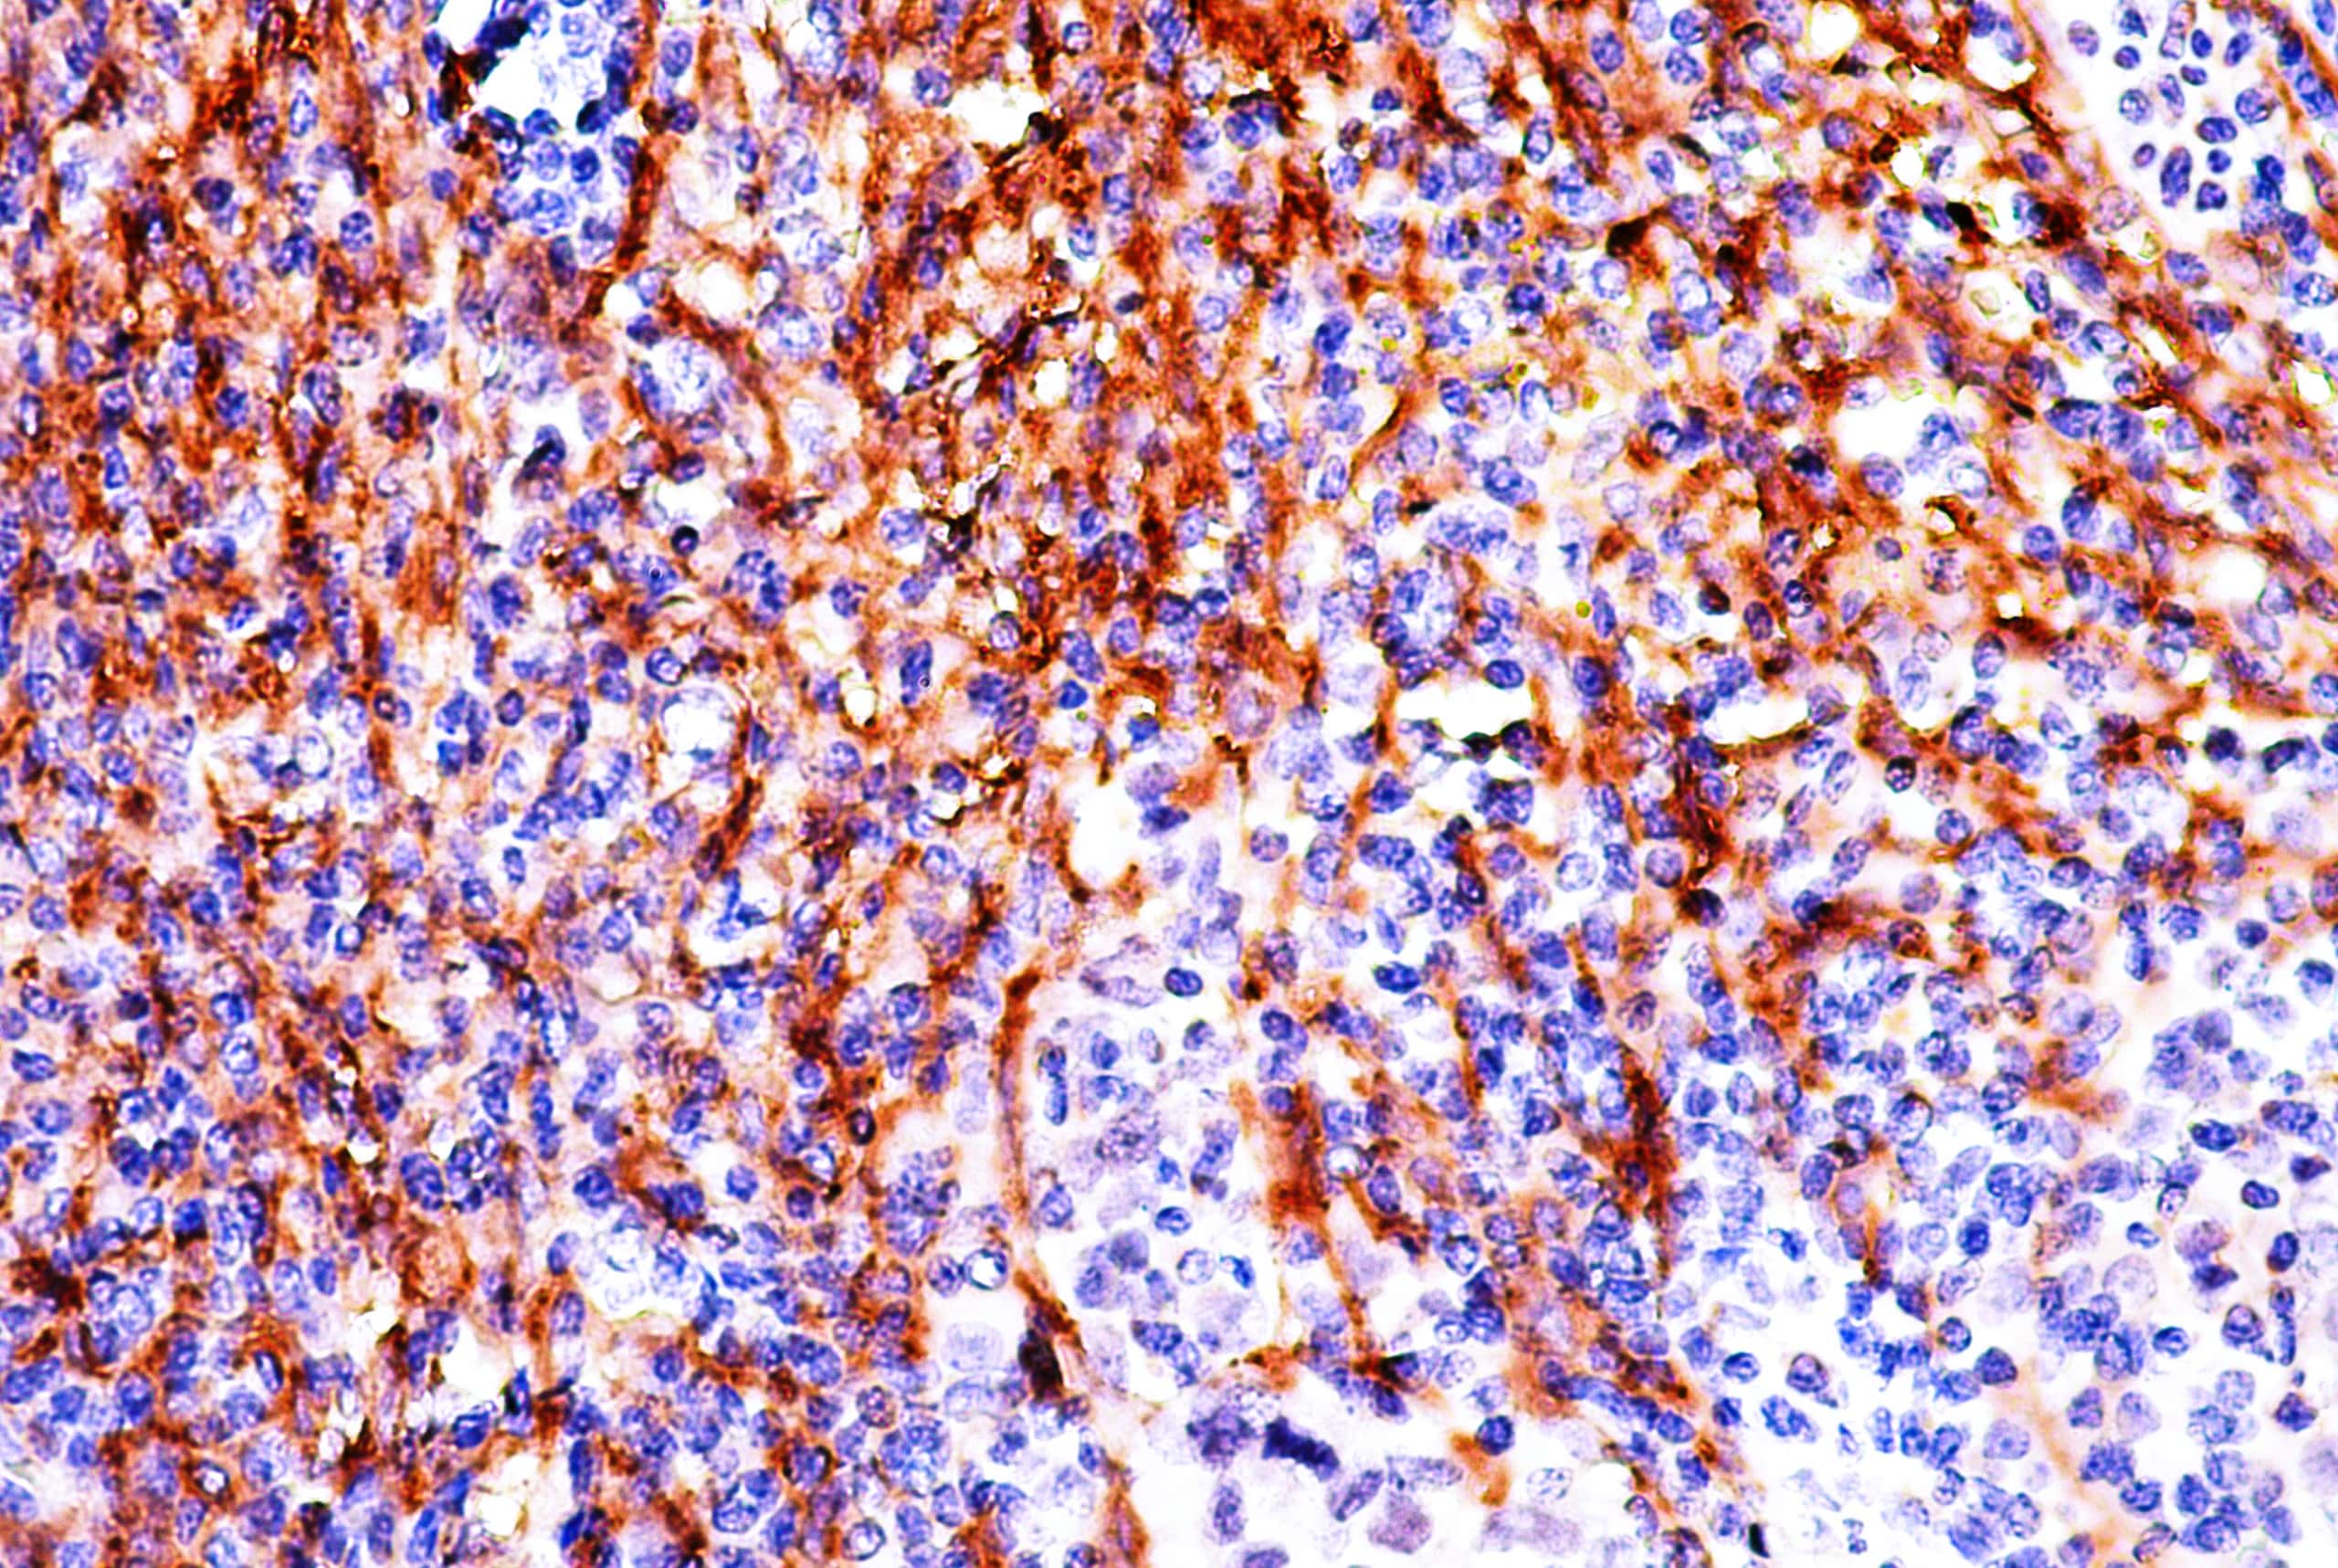
ANB95

Anti-Podoplanin[PDPN/4009R]
Podoplanin, also known as glycoprotein 36 (gp36), PA2.26 antigen, T1-alpha (T1A), and aggrus, is a 36 kDa type I transmembrane sialoglycoprotein present on the surface of podocytes in kidney glomeruli and the parietal cells of Bowman′s capsule. It is localizes in stromal cells of peripheral lymphoid tissue, follicular DCs and thymic epithelial cells. Podoplanin plays a crucial role in maintaining the unique shape of podocytes and serves as a ligand for CLEC-2. It is also directly involved in cell migration, aids metastases formation and tumor cell invasion of tissue. Research studies have shown that Podoplanin expression is upregulated in a number of tumor types including colorectal cancers, oral squamous cell carcinomas, and germ cell tumors, with higher expression levels often associated with more aggressive tumors.
| Intended Use | IVD |
|---|---|
| Antibody Type | Monoclonal |
| Clone | PDPN/4009R |
| Source | Rabbit |
| Tissue Type | Tonsil Tissue |
| Pack | 6 mL (RTU), 10 mL (RTU), 1 mL(Conc.), 0.5 mL (Conc.), 50 tests – Xmatrx Elite, 160 tests – Xmatrx Elite, 50 tests – NanoVIP, 5 slides – Manual, 5 slides – Xmatrx |